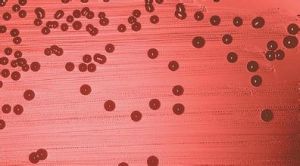
流感嗜血桿菌感染

流行病學
本菌可寄居於正常人鼻咽部,多為無莢膜菌株及副流感桿菌。泌尿生殖道偶有帶菌者。因此,①呼吸道為主要入侵門戶,引起肺部感染繼而產生菌血症、腦膜炎、心包炎、骨髓炎等;②局部軟組織經接觸感染;③泌尿生殖道感染。嬰幼兒免疫力差本菌可引起嚴重感染,成年人已具有一定免疫力因而發病者較小兒為少。成年患者多有某些基礎性疾病,如肝硬化、糖尿病惡性腫瘤、慢性梗阻性肺疾患等,因此現已成為免疫力不足的成年人重要致病菌之一,曾多次在老年人(托老所)中發生流行。
病因
根據不同的生化反應可分為6個生物型:Ⅰ、Ⅱ、ⅢⅣ、Ⅴ和Ⅵ。致病者多為Ⅰ、Ⅱ、Ⅲ和Ⅳ型。根據莢膜多糖抗原性不同,可將有莢膜菌分為a、b、c、d、e和f 6個血清型。b型致病力最強,其次為e和f。根據細菌外膜蛋白(OMP)又可分為不同的亞型有莢膜者致病力大於無莢膜者。
發病機制
本菌可引起急性化膿性炎症菌血症、敗血症。內毒素為重要致病因素,內毒素即可使實驗動物死亡有莢膜菌,特別b型可引起原發性感染無莢膜菌多引起繼發性感染,可繼發於流行性感冒、麻疹、百日咳、支氣管炎的患者。感染後可產生抗莢膜特異性抗體而獲得保護性免疫力。
臨床表現
1.肺炎 成年患者多為已有慢性呼吸系統疾患者表現為支氣管肺炎節段性肺炎,甚至大葉性肺炎半數胸膜受累但發生膿胸者少見。80%為有莢膜的b型菌引起,但亦有部分患者為無莢膜菌引起。預後取決於患者原來的健康狀況,病死率可達30%以上。
2.腦膜炎 嬰幼兒的化膿性腦膜炎60%以上由本菌引起從50年代到80年代5歲以下小兒發病率上升了6倍。過去成年人發病率低約為1%~3%,但近年來發病率亦在上升有報導已達20%成年人多有原發病灶如鼻旁竇炎肺炎、會厭炎等,特別易發生於頭部創傷或有腦脊液漏者致病菌多為b型菌。臨床表現、腦脊液檢查均與其他化膿性腦膜炎相似。病死率成人為10%~20%。
3.會厭炎 患者多為身體健康而較年輕者。發熱、咽痛由於局部嚴重腫脹可導致呼吸道堵塞,為本病死亡的主要原因。曾見由甲院轉往乙院時即因氣道堵塞而死亡的成年病例。
4.泌尿生殖道及婦產科感染 本菌可引起子宮內膜炎、輸卵管炎及膿腫、宮頸炎、陰道炎、尿道炎、產褥熱新生兒菌血症等。細菌多分不出血清型,生物型有Ⅰ、ⅡⅢ、Ⅳ。Ⅰ、ⅡⅢ多見於呼吸道感染,Ⅳ型則較獨特地見於泌尿生殖道感染,故有人將分不出血清型的生物Ⅳ型菌稱為泌尿生殖道型。
5.其他 流感嗜血桿菌還可引起其他化膿性感染:①闌尾炎:有人對376例手術切下闌尾標本進行細菌培養本菌占4%;②膽道感染:可引起慢性膽囊炎和膽石症;③蜂窩織炎:多見於小兒;④化膿性關節炎:可單一關節也可多關節受累;⑤鼻旁竇炎;⑥骨髓炎;⑦附睪炎;⑧乳突炎等。
併發症:
流感嗜血桿菌還可引起其他化膿性感染:①闌尾炎;②膽道感染;③化膿性關節炎;④鼻旁竇炎;⑤骨髓炎;⑥附睪炎;⑦乳突炎等。
診斷
診斷應綜合以下幾方面的檢查結果。
1.臨床表現 流感嗜血桿菌可引起全身多部位的感染。局部感染可有中耳炎、鼻竇炎乳突炎、會厭炎和皮膚軟組織感染等。全身感染可有肺炎、腦膜炎、心內膜炎、骨髓炎、化膿性骨關節炎、泌尿生殖道感染等。慢性呼吸道感染則應考慮到副流感嗜血桿菌感染的可能。
2.流行病學資料 正常人鼻咽部帶菌率較高(20%~40%),但血清中具有保護水平抗體者很少患病,患者以5歲以下小兒最為多見,特別是2個月至2歲的嬰兒感染率最高。成年人中以老年人以及免疫功能受到損傷者(糖尿病、肝硬化、惡性腫瘤患者,以及接受放射、化學免疫抑制劑治療和HIV感染者)亦成為本菌感染的易感者。
3.實驗室檢查 最重要者為病原學檢查。儘快進行血尿、膿痰及脊液等標本的細菌培養,同時做膿、痰、腦脊液的塗片細菌檢查,用ELISA檢查血清中的特異性IgM抗體,用反向血凝查細菌的抗原。
鑑別診斷:
主要依據細菌培養和血清免疫學檢查的結果。
檢查
實驗室檢查:
1.血象 血白細胞輕症者可在正常範圍,重症者則可增高達10×109/L以上,中性可占80%以上
2.腦脊液檢查 與其他化膿菌引起者相似,蛋白增多糖和氯化物減少,白細胞增多達1000×106/L以上,多核細胞占多數。
3.病原學檢查
(1)塗片直接檢查:肺炎患者的痰,腦膜炎患者的腦脊液,化膿性感染病灶處膿性分泌物,均可做塗片染色檢查,如發現革蘭陰性短桿菌有助於診斷
(2)細菌培養:血、腦脊液和尿培養出細菌可為確診依據。咽培養和痰培養則不能除外為帶菌所致,須結合臨床及其他檢查綜合考慮。既往採用的朱古力培養基尚不夠敏感國內鄧光貴等報導用改良的GCYSB培養基,對本菌的檢出率比朱古力培養基高分別為43.1%和12.9%。可用玻片凝集試驗和莢膜膨脹試驗確定細菌的型別
(3)細菌核酸檢查:已有人在試用聚合酶鏈反應法檢查細菌特異性核酸片段,但敏感性和特異性尚不夠穩定,仍在研究中。
(4)免疫學檢查:用酶聯免疫吸附試驗檢測特異性IgM抗體,用反向血凝試驗檢測細菌抗原,比細菌培養更快獲得結果
(5)其他檢查:依據患者感染部位可選擇進行X線拍片、CT等檢查以協助診斷。
其它輔助檢查:
肺炎者X線表現與肺炎球菌肺炎相似。
治療
1.一般及對症治療 根據患者的不同疾病給予相應的對症處理例如肺炎患者的祛痰鎮咳,腦膜炎患者的脫水降顱壓及防治腦水腫等。
2.病原學治療 既往主要套用氨苄西林和青黴素,近年來耐藥菌株明顯增多而改用敏感性尚高的氯黴素、氟喹諾酮類藥、第三代頭孢菌素、紅黴素(包括羅紅黴素和阿奇黴素)等劑量和療程依據病情輕重而定,輕症者可口服用藥,重症者則應靜脈給藥。對腦膜炎患者則應選用能透過血-腦屏障,在腦脊液中能達到有效治療濃度的藥物,如氯黴素、頭孢噻肟、頭孢曲松等。由於細菌的耐藥情況不斷地變化著,故應依據當地的藥敏情況選用藥物,待患者的細菌藥敏結果出來後予以調整。
預後預防
預後:
由於本菌多感染嬰幼兒和免疫功能低下的成年人,故嚴重感染者均有一定的病死率,如肺炎和腦膜炎的病死率在10%~30%。預後的好壞和患者原來的健康狀況有關。
預防:
傳染源的管理方面,應徹底治癒患者,使其病原菌確切陰轉,但對廣大鼻咽部帶菌者則難以管理切斷呼吸道傳播途徑亦缺少效果肯定的有效辦法。故本病的預防主要措施為實施主動免疫的疫苗接種。最初用單純b型菌的莢膜聚核糖磷酸鹽(PRP)做疫苗,免疫效果不理想。後試用了多種結合疫苗,即PRP與白喉類毒素或破傷風類毒素,或百日咳、腦膜炎奈瑟菌B群的外膜蛋白等組成結合疫苗,明顯地提高了免疫效果,保護率提高到80%~90%。Granoff等給新生兒先注射白喉和破傷風疫苗後,再接種PRP與破傷風的結合疫苗,獲得的抗體比單用結合疫苗者高2~3倍。Englund等給妊娠第三期孕婦接種:PRP與白喉類毒素結合疫苗,分娩時血中抗體為171µg/L,對照組為1.2µg/L,臍帶血中分別為29.3µg/L和0.29µg/L這種免疫方法,既有利於孕產婦,也可保護新生兒。